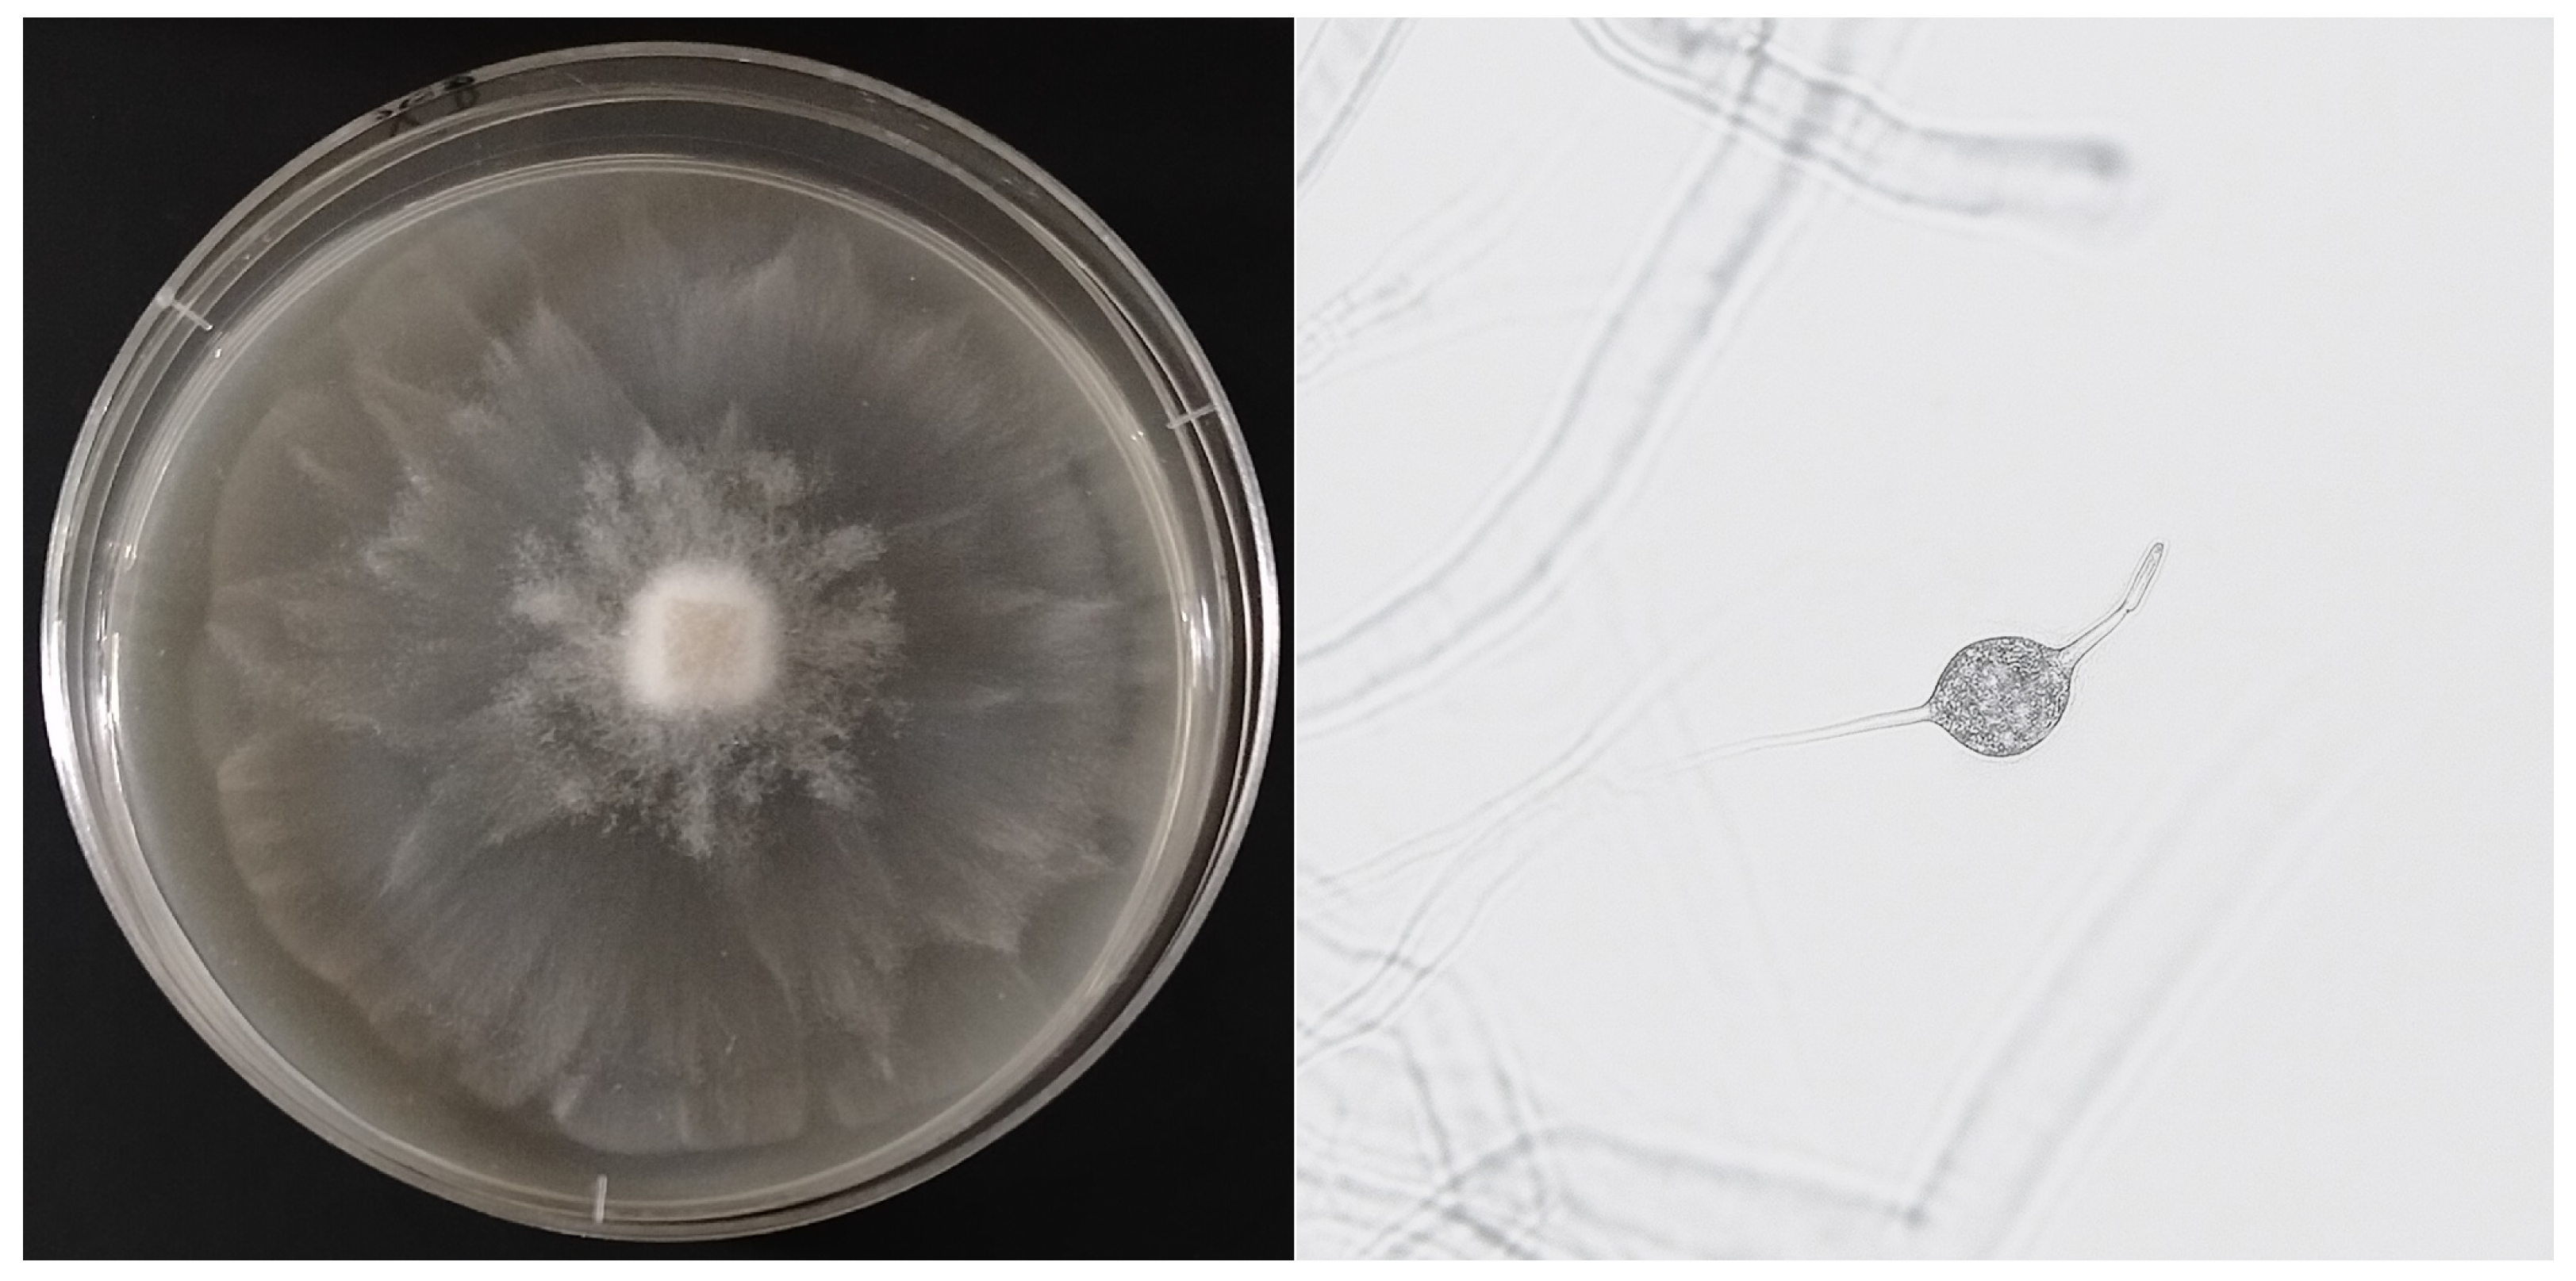
Forests 16 01736 g006

Urban Pathways of Oomycete Dissemination: A Case Study from Warsaw Parks
Abstract
1. Introduction
2. Materials and Methods
2.1. Description of the Study Sites
2.1.1. Ujazdowski Park (Śródmieście District, Warsaw)
2.1.2. Skaryszewski Park Named After I.J. Paderewski—Duck Pond (Praga-Południe District, Warsaw)
2.1.3. Linear Park over the Southern Bypass of Warsaw (Ursynów District; Section Along F. Płaskowickiej Street, near Stryjeńskich Street)
2.2. Fieldwork
2.3. Laboratory Analyses
2.4. Preparation of Isolates for Microscopic Observation
2.5. Molecular Analyses
3. Results
3.1. Ujazdowski Park
3.2. Skaryszewski Park (Duck Pond)
3.3. Linear Park Along the Southern Bypass of Warsaw
4. Discussion
4.1. Spread of Oomycetes in Urban Areas
4.2. Introduction via Plant Material
4.3. Birds as Vectors
4.4. Waterborne Transport—Runoff and Stream Spread
4.5. Human Transmission via Footwear
4.6. Taxonomic and Epidemiological Significance: Phytophthora cactorum and Phytopythium mntanum
4.7. Integration of Dispersal Mechanisms and Risk Management Implications
5. Conclusions
Author Contributions
Funding
Data Availability Statement
Conflicts of Interest
References
- Dale, A.; Frank, S. Warming and drought combine to increase pest insect fitness on urban trees. PLoS ONE 2017, 12, e0173844. [Google Scholar] [CrossRef] [PubMed]
- Kabisch, N.; van den Bosch, M.; Lafortezza, R. The health benefits of nature-based solutions to urbanization challenges for children and the elderly—A systematic review. Environ. Res. 2017, 159, 362–373. [Google Scholar] [CrossRef]
- Konijnendijk, C.C.; Ricard, R.M.; Kenney, A.; Randrup, T.B. Defining urban forestry–A comparative perspective of North America and Europe. Urban For. Urban Green. 2006, 4, 93–103. [Google Scholar] [CrossRef]
- Jung, T.; Pérez-Sierra, A.; Durán, A.; Jung, M.; Balci, Y.; Scanu, B. Canker and decline diseases caused by soil-and airborne Phytophthora species in forests and woodlands. Persoonia-Mol. Phylogeny Evol. Fungi 2018, 40, 182–220. [Google Scholar] [CrossRef]
- Hansen, M.; Olivieri, I.; Waller, D.; Nielsen, E.; Group, G.W. Monitoring adaptive genetic responses to environmental change. Mol. Ecol. 2012, 21, 1311–1329. [Google Scholar] [CrossRef]
- Erwin, D.; Ribeiro, O.K. Phytophthora Diseases Worldwide; American Phytopathological Society: St Paul, MN, USA, 1996. [Google Scholar]
- Abad, Z.G.; Burgess, T.; Bourret, T.; Bensch, K.; Cacciola, S.; Scanu, B.; Mathew, R.; Kasiborski, B.; Srivastava, S.; Kageyama, K.; et al. Phytophthora: Taxonomic and phylogenetic revision of the genus. Stud. Mycol. 2023, 160, 259–348. [Google Scholar] [CrossRef] [PubMed]
- Safaiefarahani, B.; Mostowfizadeh-Ghalamfarsa, R.; Hardy, G.; Burgess, T. Re-evaluation of the Phytophthora cryptogea species complex and the description of a new species, Phytophthora pseudocryptogea sp. nov. Mycol. Prog. 2015, 14, 108. [Google Scholar] [CrossRef]
- Brasier, C. The biosecurity threat to the UK and global environment from international trade in plants. Plant Pathol. 2008, 57, 792–808. [Google Scholar] [CrossRef]
- Jung, T.; Orlikowski, L.; Henricot, B.; Abad-Campos, P.; Aday, A.; Aguín Casal, O.; Bakonyi, J.; Cacciola, S.O.; Cech, T.; Chavarriaga, D.; et al. Widespread Phytophthora infestations in European nurseries put forest, semi-natural and horticultural ecosystems at high risk of Phytophthora diseases. For. Pathol. 2016, 46, 134–163. [Google Scholar] [CrossRef]
- Hong, C.; Moorman, G. Plant pathogens in irrigation water: Challenges and opportunities. Crit. Rev. Plant Sci. 2025, 24, 189–208. [Google Scholar] [CrossRef]
- Grünwald, B.; Schoeps, B.; Krüger, A. Recognizing the molecular multifunctionality and interactome of TIMP-1. Trends Cell Biol. 2019, 29, 6–19. [Google Scholar] [CrossRef]
- Santini, A.; Ghelardini, L.; De Pace, C.; Desprez-Loustau, M.; Capretti, P.; Chandelier, A.; Stenlid, J. Biogeographical patterns and determinants of invasion by forest pathogens in Europe. New Phytol. 2013, 197, 238–250. [Google Scholar] [CrossRef] [PubMed]
- Eschen, R.; Britton, K.; Brockerhoff, E.; Burgess, T.; Dalley, V.; Epanchin-Niell, R.; Gupta, K.; Hardy, G.E.S.J.; Huang, Y.; Kenis, M.; et al. International variation in phytosanitary legislation and regulations governing importation of plants for planting. Environ. Sci. Policy 2015, 51, 228–237. [Google Scholar] [CrossRef]
- Green, S.; Cooke, D.; Dunn, M.; Barwell, L.; Purse, B.; Chapman, D.; Valatin, G.; Schlenzig, A.; Barbrook, J.; Pettitt, T.; et al. PHYTO-THREATS: Addressing threats to UK forests and woodlands from Phytophthora; identifying risks of spread in trade and methods for mitigation. Forests 2021, 12, 1617. [Google Scholar] [CrossRef]
- Barwell, L.; Purse, B.; Green, S.; Hardy, G.; Scott, P.; Williams, N.; Cooke, D.E.; Perez-Sierra, A.; Burgess, T.I.; Chapman, D. Trait-mediated filtering of Phytophthora pathogen invasions through global horticultural trade networks. New Phytol. 2025. [Google Scholar] [CrossRef]
- Jung, T.; Blaschke, H.; Neumann, P. Isolation, identification and pathogenicity of Phytophthora Species from Declining Oak Stands. Eur. J. For. Pathol. 1996, 26, 253–272. [Google Scholar] [CrossRef]
- Jung, T. Beech decline in Central Europe driven by the interaction between Phytophthora infections and climatic extremes. For. Pathol. 2009, 39, 73–94. [Google Scholar] [CrossRef]
- Jung, T.; Blaschke, M. Phytophthora root and collar rot of alders in Bavaria: Distribution, modes of spread and possible management strategies. Plant Pathol. 2004, 53, 197–208. [Google Scholar] [CrossRef]
- Tkaczyk, M.; Sikora, K. First report of the occurrence of Phytophthora honggalleglyana in an urban green space in Poland. Urban For. Urban Green. 2025, 108, 128834. [Google Scholar] [CrossRef]
- White, T.; Bruns, S.; Taylor, J.W. Amplification and direct sequencing of fungal ribosomal RNA genes for phylogenetics. In Proceedings of the PCR Protocols: A Guide to Methods and Applications; Academic Press Inc.: Cambridge, MA, USA, 1990. [Google Scholar]
- Cooke, D.; Drenth, A.; Duncan, J.; Wagels, G.; Brasier, C. A molecular phylogeny of Phytophthora and related oomycetes. Fungal Genet. Biol. 2000, 30, 17–32. [Google Scholar] [CrossRef]
- Robideau, G.; De Cock, A.; Coffey, M.; Voglmayr, H.; Brouwer, H.; Bala, K.; Chitty, D.W.; Désaulniers, N.; Eggertson, Q.A.; Gachon, C.M.; et al. DNA barcoding of oomycetes with cytochrome c oxidase subunit I and internal transcribed spacer. Mol. Ecol. Resour. 2011, 11, 1002–1011. [Google Scholar] [CrossRef]
- Oszako, T.; Sikora, K.; Belbahri, L.; Nowakowska, J. Molecular analysis of Phytophthora species found in Poland. Folia For. Polonica. Ser. A. For. 2017, 59, 321–328. [Google Scholar] [CrossRef]
- Oszako, T.; Żółciak, A.; Tulik, M.; Tkaczyk, M.; Stocki, M.; Nowakowska, J. Influence of Bacillus subtilis and trichoderma asperellum on the development of birch seedlings infected with fine root pathogen phytophthora plurivora. Sylwan 2019, 163, 1006–1015. [Google Scholar]
- Tkaczyk, M.; Sikora, K.; Galko, J.; Kunca, A. Incidence and pathogenicity of Phytophthora species in beech (Fagus sylvatica L.) stands in Slovakia. J. Plant Dis. Prot. 2023, 130, 1091–1099. [Google Scholar] [CrossRef]
- Bełka, M.; Baranowska, M.; Breza, K. Patogeniczne lęgniowce w szkółce leśnej Trawice w Nadleśnictwie Lipusz. ACTA Sci. Pol. Silv. Colendar. Ratio Ind. Lignar. 2019, 18, 135–140. [Google Scholar]
- Tkaczyk, M.; Sikora, K.; Galko, J.; Kunca, A.; Milenković, I. Isolation and pathogenicity of Phytophthora Species from Sessile Oak (Quercus petraea (Matt.) Liebl.) Stands in Slovakia. For. Pathol. 2020, 50, e12632. [Google Scholar] [CrossRef]
- Donald, F.; Purse, B.; Green, S. Investigating the role of restoration plantings in introducing disease—A case study using Phytophthora. Forests 2021, 12, 764. [Google Scholar] [CrossRef]
- Malewski, T.; Brzezińska, B.; Belbahri, L.; Oszako, T. Role of avian vectors in the spread of Phytophthora species in Poland. Eur. J. Plant Pathol. 2019, 155, 1363–1366. [Google Scholar] [CrossRef]
- Dadam, D.; Siasou, E.; Woodward, S.; Clark, J. Migratory passerine birds in Britain carry Phytophthora ramorum inoculum on their feathers and “feet” at low frequency. For. Pathol. 2020, 50, e12569. [Google Scholar] [CrossRef]
- Okorski, A.; Paczkowska, G.; Dąbrowska, J.; Rutkiewicz, A.; Borowik, P.; Pszczółkowska, A.; Oszako, T. Characterization of the mycobiome of Pinus sylvestris L. seedlings damaged by forest animals, with an emphasis on pathogenic species. Eur. J. Plant Pathol. 2025, 171, 201–222. [Google Scholar] [CrossRef]
- Nechwatal, J.; Oßwald, W. Pythium montanum sp. nov., a new species from a spruce stand in the Bavarian Alps. Mycol. Prog. 2003, 2, 73–80. [Google Scholar] [CrossRef]
- Ptaszek, M.; Orlikowski, L. Occurrence of Phytophthora species in watercourses and reservoirs in Poland and the threat to cultivated plants by this genera. Prog. Plant Prot. 2015, 55, 64–70. [Google Scholar] [CrossRef]
- Kliejunas, J. Sudden Oak Death and Phytophthora Ramorum: A Summary of the Literature; Gen. Tech. Rep. PSW-GTR-234; US Department of Agriculture, Forest Service, Pacific Southwest Research Station: Albany, CA, USA, 2010. [Google Scholar]
- Tkaczyk, M.; Sikora, K.; Nowakowska, J.; Anisko, E.; Oszako, T.; Belbahri, L.; Milenkovic, I. Four different Phytophthora species that are able to infect Scots pine seedlings in laboratory conditions. Folia For. Polonica. Ser. A For. 2016, 58, 123–130. [Google Scholar] [CrossRef]
- Chen, X.; Wen, K.; Zhou, X.; Zhu, M.; Liu, Y.; Jin, J.; Nellist, C. The devastating oomycete phytopathogen Phytophthora cactorum: Insights into its biology and molecular features. Mol. Plant Pathol. 2023, 24, 1017–1032. [Google Scholar] [CrossRef] [PubMed]
- Fabre, F.; Coville, J.; Cunniffe, N. Optimising reactive disease management using spatially explicit models at the landscape scale. In Plant Diseases and Food Security in the 21st Century; Springer International Publishing: Cham, Switzerland, 2021; pp. 47–72. [Google Scholar]

Disclaimer/Publisher’s Note: The statements, opinions and data contained in all publications are solely those of the individual author(s) and contributor(s) and not of MDPI and/or the editor(s). MDPI and/or the editor(s) disclaim responsibility for any injury to people or property resulting from any ideas, methods, instructions or products referred to in the content. |
© 2025 by the authors. Licensee MDPI, Basel, Switzerland. This article is an open access article distributed under the terms and conditions of the Creative Commons Attribution (CC BY) license (https://creativecommons.org/licenses/by/4.0/).
Share and Cite
Tkaczyk, M.; Sikora, K. Urban Pathways of Oomycete Dissemination: A Case Study from Warsaw Parks. Forests 2025, 16, 1736. https://doi.org/10.3390/f16111736
Tkaczyk M, Sikora K. Urban Pathways of Oomycete Dissemination: A Case Study from Warsaw Parks. Forests. 2025; 16(11):1736. https://doi.org/10.3390/f16111736
Chicago/Turabian StyleTkaczyk, Miłosz, and Katarzyna Sikora. 2025. "Urban Pathways of Oomycete Dissemination: A Case Study from Warsaw Parks" Forests 16, no. 11: 1736. https://doi.org/10.3390/f16111736
APA StyleTkaczyk, M., & Sikora, K. (2025). Urban Pathways of Oomycete Dissemination: A Case Study from Warsaw Parks. Forests, 16(11), 1736. https://doi.org/10.3390/f16111736






